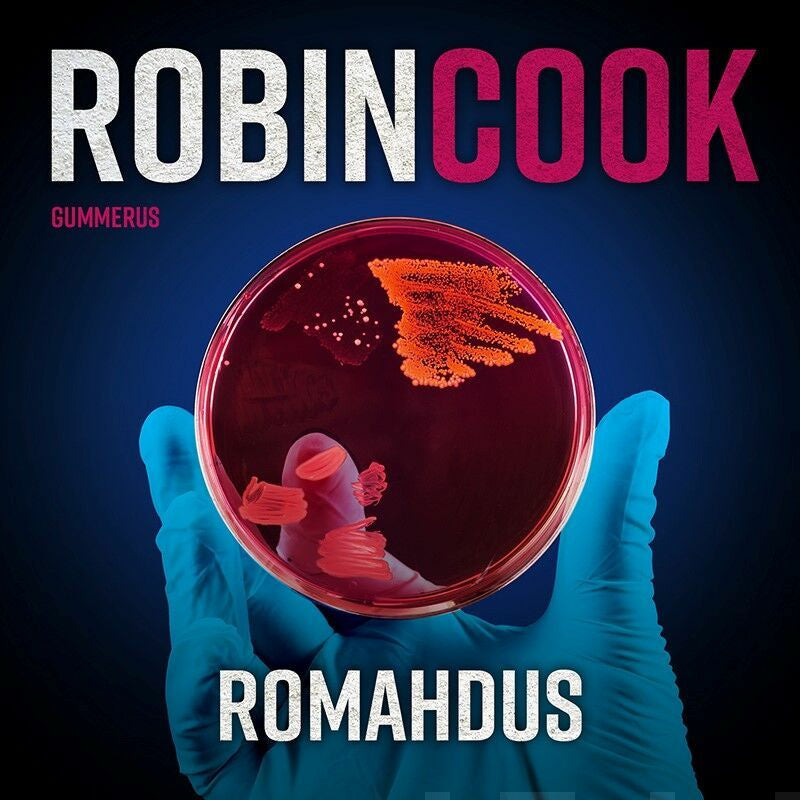

Romahdus
Angela Dawsonin maailma alkaa luhistua. Ärhäkkä sairaalabakteeri leviää hänen johtamansa firman yksityissairaaloissa ja tappaa potilaita, eikä rahoitusongelmien kanssa kamppailevalla yhtiöllä ole varaa skandaaliin. Angelan ahdinkoa syventää kuolinsyyntutkija Laurie Montgomery, joka ei malta pysyt... Lue lisää
Angela Dawsonin maailma alkaa luhistua. Ärhäkkä sairaalabakteeri leviää hänen johtamansa firman yksityissairaaloissa ja tappaa potilaita, eikä rahoitusongelmien kanssa kamppailevalla yhtiöllä ole varaa skandaaliin. Angelan ahdinkoa syventää kuolinsyyntutkija Laurie Montgomery, joka ei malta pysyt... Lue lisää
- Kustantaja / Valmistaja Gummerus
- ISBN 9789512434091
- Tuotekoodi 9789512434091
- Kirjoittajat Robin Cook
- Kääntäjät Jorma-Veikko Sappinen
- Lukijat Panu Kangas
- Kieli Suomi
- Alkuperäinen kieli Englanti
- Thema-luokitus Dekkarit; Käännetty kaunokirjallisuus
- Ilmestymispäivä 10.04.2023
- Vuosi 2023
- Tuoteryhmä Äänikirjat, kauno
- Tuotepääryhmä Ladattavat tuotteet
- Tuotelinja Kirjat
- Genretunnus JA
- Kesto 15h:22min:00s
- Avainsanat trillerit; psykologiset trillerit; sairaalatrillerit
- Kirjastoluokka 84.2
- Alkuperäinen nimi Critical
- Sähkökirjan suojaus Digital watermarking
- Tuotemuoto Ladattava äänitiedosto
- Tuotemuodon lisätiedot MP3
- Tuoteturvallisuusyhteystiedot Gummerus Kustannus Oy, info@gummerus.fi, PL 1000, Käenkuja 3 A, 3.krs, 00501, Helsinki
- ALV 14,0%
Tämä tuote kuuluu tuoteryhmiin
Tuotearvostelut Suomalainen.comissa
Tutustu tuotearvostelujen käytäntöihin ja ehtoihin ennen kuin jätät arvostelun.
Suomalainen.com -verkkokaupassa on mahdollista jättää tuotearvosteluja siellä myynnissä olevista tuotteista. Tuotearvosteluja voivat jättää sekä tuotetta Suomalaisesta Kirjakaupasta ostaneet asiakkaat että muut sivuston käyttäjät. Arvostelijan nimimerkin jälkeinen teksti kertoo, onko kyseessä vahvistettu ostaja vai muu asiakas/sivuston käyttäjä.
-
Vahvistettu ostaja - Kyseinen arvostelu on jätetty käyttämällä tuotteen ostajalle lähetettyä sähköpostilinkkiä. Kyseessä on siis vahvistettu ostaja eli arvostelun jättänyt henkilö on ostanut todennetusti kyseisen tuotteen.
-
Vahvistettu suosittelija - Kyseinen arvostelu on jätetty suomalainen.com -verkkosivustolla. Arvostelijan sähköpostiosoite on vahvistettu, jotta on voitu varmistua siitä, että arvostelun on jättänyt oikea henkilö. Suomalainen.com ei kuitenkaan ole vahvistanut, että kyseinen henkilö on ostanut tuotteen.
- Ei tekstiä nimimerkin jälkeen - Kyseinen arvostelu on jätetty suomalainen.com -verkkosivustolla, mutta arvostelun jättäjän sähköpostiosoitetta ei ole vahvistettu.
Tuotearvostelussa pakollisia tietoja ovat tuotteen pistemäärä (tähdet), otsikko sekä arvosteluteksti. Jos jätät arvostelun sinulle lähetetyn sähköpostilinkin kautta, arvostelu julkaistaan käyttämällä etunimeäsi sekä sukunimen ensimmäistä kirjainta.
Jos jätät arvostelun sivustollamme, voit käyttää arvostelussa myös nimimerkkiä. Arvostelun jättämisen yhteydessä sinulta kysytään sähköpostiosoitetta, jonka avulla vahvistamme, että arvostelun on lähettänyt oikea henkilö, eikä esimerkiksi robotti. Tuotearvostelujen palveluntarjoajana toimii Yotpo. Katso Yotpon tietosuojaseloste.
Arvostelut julkaistaan tuotteen kohdalla automaattisesti ja ne tulevat esiin viiveellä. Suomalainen.com pidättää kuitenkin oikeuden poistaa kommentit, jotka sisältävät epäasiallista, herjaavaa tai halventavaa kieltä, vihapuhetta tai ovat muuten hyvän tavan vastaisia, tai joissa markkinoidaan muiden toimijoiden sivustoja tai tuotteita.
Jättämällä arvostelun annat Suomalaiselle Kirjakaupalle oikeuden käyttää kyseisiä arvosteluja omassa markkinoinnissaan (sekä painettu että digitaalinen) ilman erillistä korvausta. Arvosteluja käytetään myös analysointiin ja markkinoinnin kehittämiseen.
Tuotearvostelun jättäneiden kesken arvotaan säännöllisin väliajoin tuotepalkintoja. Tutustu arvonnan sääntöihin täällä.
Mikäli haluat poistaa jättämäsi tuotearvostelun verkkokaupastamme, pyyntö tästä tulee ohjata asiakaspalveluumme: asiakaspalvelu@suomalainen.com.
Tuotearvostelut eivät ole tarkoitettu asiakasreklamaatioiden tai tilauskyselyjen tekemiseen. Reklamaatiotapauksissa pyydämme ottamaan yhteyttä asiakaspalveluumme: asiakaspalvelu@suomalainen.com.
Jättämällä arvostelun suomalainen.com -verkkokauppaan hyväksyt yllämainitut käytännöt ja ehdot.
Lue lisää tuotearvosteluista.